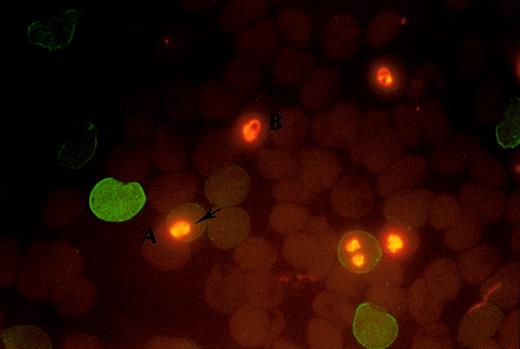
Fig. 1. Fluorescence staining of the blood group antigen. / The positive fluorescence staining shows on A+ RBC with abnormal hemoglobin (A) and the negative staining shows on B+ RBC with normal hemoglobin (B). The intracellular parasites were stained by EB (arrow).

Hemoglobin E is very common in parts of Southeast Asia. The possible malaria protective effects of this and other inherited hemoglobin abnormalities prevalent in Thailand were assessed in a mixed erythrocyte invasion assay. In vitro, starting at 1% parasitemia,Plasmodium falciparum preferentially invaded normal (HbAA) compared to abnormal hemoglobin (HbH, AE, EE, HCS, β-thalassemia E) red cells (HRBCs). The median (range) ratio of parasitization of HRBCs (n = 109) compared to the controls of different major blood groups was 0.40 (0.08, 0.98), less than half that of the normal red cells (NRBCs) compared to their controls 0.88 (0.53, 1.4;P = .001). The median (range) parasitemia in the HRBCs was 2% (0.1%-9%) compared to 5.2% (1.2%-16.3%) in the NRBCs (P = .001). The proportion of the RBC population that is susceptible to malaria parasite invasion can be described by a selectivity index (SI; observed number of multiply invaded RBCs/number predicted). The heterozygote AE cells differed markedly from all the other cells tested with invasion restricted to approximately 25% of the RBCs; the median (range) SI was 3.8 (1-15) compared with 0.75 (0.1-0.9) for EE RBCs (P < .01). Despite their microcytosis, AE cells are functionally relatively normal in contrast to the RBCs from the other hemoglobinopathies studied. These findings suggest that HbAE erythrocytes have an unidentified membrane abnormality that renders the majority of the RBC population relatively resistant to invasion by P falciparum. This would not protect from uncomplicated malaria infections but would prevent the development of heavy parasite burdens and is consistent with the “Haldane” hypothesis of heterozygote protection against severe malaria for hemoglobin E.
Introduction
The progression to disease and sometimes death from malaria is determined by several factors including the level of host immunity, the innate resistance characteristics of the host, and the virulence of the infecting parasites. Innate host resistance is manifest by inherited red blood cell (RBC) characteristics such as the Duffy blood group determinant Fya Fyb, which renders the RBCs resistant to invasion by Plasmodium vivax, alterations in the erythrocyte membrane as in ovalocytosis, deficiency in glucose-6-phosphate dehydrogenase, or abnormalities of hemoglobin composition as in thalassemia or sickle cell trait. In 1949, J. B. S. Haldane hypothesized that the high gene frequencies of hemoglobinopathies in malaria-endemic areas may have resulted from protection conferred against malaria—a major cause of death in the tropics. This resulted in an equilibrium or “balanced polymorphism” in which the homozygote hematologic disadvantage was balanced by the heterozygote advantage of protection from malaria. This hypothesis has been supported by many studies1-6 and is now generally accepted. Hemoglobin E, resulting from a single point mutation (Glu→Lys) at codon 26 of the β-globin gene, is common in Southeast Asia. Whereas early laboratory studies suggested that hemoglobin E (HbE) retarded intraerythrocytic growth of Plasmodium falciparum,7 subsequent investigations have yielded conflicting results.8 Cross-sectional epidemiologic studies have also given contradictory results,9,10although these were focused on risk of infection and not on disease severity. Recently, in a hospital-based study in Thailand, the presence of HbE trait (HbAE) was associated with reduced disease severity in acute P falciparum malaria.11
The mechanisms underlying malaria protection by these genetic RBC variants have been studied extensively and can be classified into several broad groups: (1) reduced probability of merozoite invasion into the variant RBCs, (2) impairment of parasite growth within the variant RBCs, (3) enhanced removal of the parasitized variant RBCs, and (4) enhanced probability of infection early in life, particularly withP vivax, which protects against subsequent severe P falciparum malaria.12 Nevertheless despite considerable research, the relative roles of these processes and the cellular mechanisms that mediate resistance of many of these genetic RBC variants to malaria parasites remain unclear.
To evaluate the susceptibility of RBCs to invasion by malaria parasites, the RBCs must be studied under standardized conditions ex vivo. We have addressed the problems associated with variation in culture conditions, and thus invasion/growth rate differences between experiments, by cultivating different “abnormal” RBCs mixed with an equal proportion of control cells and relating differences only to the control values. RBC susceptibility is a major determinant of the severity of malaria infection. We have shown recently that only one eighth of the normal RBC population in vivo is susceptible to P vivax infection, and that in uncomplicated P falciparum malaria only one third to one half of the RBC population is available for invasion, whereas in severe malaria there is no evidence of RBC selectivity.13 Nonselective invasion is therefore a virulence determinant associated with higher multiplication rates at high parasite densities and resultant larger parasite biomasses.14 In this study, possible protective mechanisms against severe P falciparum malaria were assessed by measuring the relative susceptibility to parasite invasion of hemoglobinopathic RBCs compared to RBCs with a normal hemoglobin type at high parasite densities. The studies were performed at relatively high parasite densities designed to reflect progression to heavy parasitemias and severe infection.
Patients and methods
Abnormal hemoglobin RBCs
Heparinized blood samples were obtained from routine samples taken from patients attending the Thalassemic Center, Siriraj Hospital, Bangkok, Thailand. Blood samples were placed immediately at 4°C and were always used within 24 hours. No blood transfusion had been administered to these patients for at least 3 months before this study. The patient's history of splenectomy was recorded. The hemoglobin abnormality was determined by either hemoglobin electrophoresis on a cellulose acetate membrane or using an automatic high-performance liquid chromatography system (Variant, Biorad, London, United Kingdom).15 Criteria for identification of the variations were as described previously.16 17 The ABO blood group was determined by hemagglutination with antibodies specific to blood group antigens. Hemoglobin concentration, RBC index, mean cell volume (MCV), and mean cell hemoglobin (MCH) were measured automatically by a Coulter S Plus (Coulter Electronics, London, United Kingdom). The RBCs were washed 3 times in RPMI 1640 and resuspended in malaria culture medium to give a hematocrit of 5%.
Control RBCs
Fresh RBCs from healthy donors (n = 34; A+ = 12, B+ = 12, and O+ = 10) were obtained in heparinized tubes. ABO blood group and hemoglobin typing were tested as described above. The RBCs were washed 3 times and resuspended at 50% hematocrit in RPMI supplemented with 10% AB serum and used for parasite culture within 3 days. The intervals between venipuncture and parasite culture for abnormal and normal RBCs were similar.
Parasite culture
P falciparum, 4 Thai strains, each of a single genotype (TM267R, TAB106, TAB169, and TAB183), were maintained in continuous culture in fresh normal blood group A, B, or O RBCs in RPMI 1640 medium supplemented with 10% heat-inactivated human AB+ serum and 2 μmol/L glutamine, 25 mM Hepes, and 20 μg/mL gentamicin (MCM) at 37°C, in an atmosphere of 5% CO2 using standard methods.18 Parasites were stage-synchronized by sorbitol lysis19 or Percoll gradient purification.16 The mature schizont stages, cultured at 2% parasitemia and 5% hematocrit, were used to generate merozoites for the invasion assay.
Assessment of RBC susceptibility to P falciparuminvasion
The parasite cultures in fresh RBCs containing 2% synchronized schizont-infected RBCs at 5% hematocrit were mixed with an equal number of a 5% suspension of “abnormal hemoglobin” RBCs to give a final parasitemia of 1%. The number of cells added was based on direct RBC counts. Parasite cultures in normal A, B, or O RBCs were chosen so that the major blood group differed from that of the abnormal RBCs in the test before mixing. Cultures mixed with normal and abnormal RBCs (1:1) were kept under culture conditions for 24 hours. Thin films made at the start of cultures were stained with Field stain, and parasitemia was assessed by counting 1000 RBCs per slide. After 24 hours, the cultures were washed in RPMI 1640. The packed RBCs were then resuspended in fetal calf serum (FCS) at 50% hematocrit and thin blood films were made, fixed with absolute methanol, and dried for the immunofluorescence assay. Parasite cultures mixed with normal hemoglobin RBCs (HbAA) were used as controls. To determine whether it was necessary to agitate the parasite cultures to optimize invasion, 10 static cultures (5 normal AA and 5 with thalassemic RBCs) were conducted in parallel with agitated cultures of the same cells (3-dimensional rocking platform shaker STR9, Stuart Scientific, London, United Kingdom at a speed of 20 revolutions/min for 3 hours).
Immunofluorescence assay
The abnormal hemoglobin RBCs were distinguished from the normal RBCs in the cultures by immunofluorescence staining of different major blood groups as follows. Monoclonal mouse antiblood group A or B (Zymed Laboratory, no. 18006-7, San Francisco, CA; 5 μL) was placed on the demarcated area on the thin blood films, placed in a humidified chamber for 30 minutes at room temperature, then washed twice in phosphate-buffered saline. Mouse immunoglobulin Fab fragments conjugated with fluorescein isothiocyanate (Dako, no. F 0313, Glostrup, Denmark; 5 μL) were then added. After 30 minutes of incubation the slides were washed twice and mounted with 50% buffered glycerol containing 10 μg/mL ethidium bromide (EB) and examined by UV light microscopy.
Selectivity of parasite invasion into the RBCs
The number of fluorescent RBCs (those with abnormal hemoglobin) and unstained RBCs (those with normal hemoglobin, HbAA) in the cultures were counted for 1000 RBCs per slide. Parasites were counted in the 2 populations to a total of 1000 RBCs. Multiplication rates were determined for the individual cell types as final parasitemia divided by starting parasitemia. The susceptibility of the RBCs was expressed as a relative susceptibility ratio (SR) and the selectivity index (SI) determined.13 The SR was defined as the ratio of the number of malaria parasites in stained RBCs to that in the unstained RBCs divided by the ratio of the stained to the unstained RBCs used in starting cultures: relative susceptibility ratio (SR) = (stained infected RBCs/stained RBCs) ÷ (unstained infected RBCs/unstained RBCs).
The SI was determined from cultures of a single parasite isolate (TM267R) in the RBCs under investigation adjusted to 1% parasitemia as follows. An infected RBC containing more than one ring-stage parasite was classified as a multiply invaded cell. The number of multiply invaded stained and unstained RBCs was counted in a total of 300 infected RBCs. The SI was defined as the ratio of the observed proportion of multiple infected RBCs to the proportion expected from a random process (Poisson distribution)13: selectivity index (SI) = (the observed value of infected RBCs with multiple invasion) ÷ (the value expected from a Poisson distribution).
Statistical analysis
Normally distributed data were compared using the pairedt test and correlations using Pearson correlation coefficient. The relative SR of abnormal hemoglobin RBCs was compared to that of normal RBCs using the Mann-Whitney U test and Spearman correlation coefficient. The Wilcoxon signed rank test was used to test the difference between the SI and parasitemia of abnormal and normal hemoglobin RBCs within the same slide. The statistical package SPSS for windows (SPSS, Gorinchem, The Netherlands; 1998) was used for analysis. A conservative P < .01 was chosen for the level of significance.
Results
Patients
Red blood cells from 109 individuals were investigated, including 9 with HbH with Constant Spring (α-thalassemia1/CS;−−/ααcs), 13 with HbH disease (α-thalassemia1/α-thalassemia2; αoα+;−−/−α), 22 HbE homozygotes (HbEE), 20 HbE heterozygotes (HbAE), and 45 βo-thalassemia with HbE disease (β-thal/HbE; 17 of them had had a previous splenectomy). The 109 individuals with abnormal hemoglobin RBCs had lower values for MCV (mean (SD) = 6710 fl, and MCH (mean (SD) = 203.6 pg compared to the normal range of the normal RBCs (n = 34) (mean (SD) of MCV = 819 fl and mean (SD) of MCH = 292.4 pg, P = .001. The RBC indices of heterozygote AE subjects were MCV 782 fl and MCH 263 pg.
Parasite invasion of RBCs
In 80% of experiments the interval from blood sampling to the start of culture was less than 2 hours. In 6 samples the experiments were conducted immediately and repeated 24 hours later. The results were similar in the paired comparison. In parasite cultures, containing an equal number of normal and abnormal hemoglobin RBCs (HRBCs), the abnormal RBCs were readily distinguished from the normal RBCs (NRBCs) by positive fluorescence staining of the blood group antigens as shown in Figure 1.
Fluorescence staining of the blood group antigen.
The positive fluorescence staining shows on A+ RBC with abnormal hemoglobin (A) and the negative staining shows on B+ RBC with normal hemoglobin (B). The intracellular parasites were stained by EB (arrow).
Fluorescence staining of the blood group antigen.
The positive fluorescence staining shows on A+ RBC with abnormal hemoglobin (A) and the negative staining shows on B+ RBC with normal hemoglobin (B). The intracellular parasites were stained by EB (arrow).
There were no major differences between SR or SI values in static or agitated cultures either for normal AA (mean [95% CI]) difference of SR = −0.09 (−0.37 to 0.19) and SI = −0.09 (−0.17 to −0.01) or thalassemic RBCs (mean ([95% CI]) difference of SR = 0.03 (−0.03 to 0.09) and SI = 0.03 (−0.03 to 0.09) and so the remainder of the experiments were conducted in static cultures.
In parallel control cultures (n = 34), there were no differences in the SR values of 50:50 mixtures of normal hemoglobin RBCs (HbAA) of blood groups A, B, or O (P = .3). For all 34 donors with HbAA the median (range) SR was 0.88 (0.53-1.4), that is, not significantly different from 1. Within each slide, the proportion of parasitized HRBCs (median [range] = 2% [0.1%-9%]) was significantly lower than the number of parasitized NRBCs (median [range] = 5.2 [1.2%-16.3%]; P = .01). The median difference in parasitemia between the HRBC and NRBC counts was 3.2% (range, 1.9%-12.6%; P = .001) and the median (range) NRBC/HRBC ratio was 2.94 (0.38-58). The mean (SD) multiplication rates, from the 1% starting parasitemia in unmixed cultures (n = 10 for each group) were 3.5 (1.3) in the control cells (AA controls) and 3.5 (2.7) in the AA tested cells. These values were significantly higher than in the AE cells, 2.6 (1.7) and in the EE cells, 2.8 (1.7) (P = .03). However, the multiplication rates were significantly higher in the AA control cells in mixed cultures with thalassemic cells: 7.8 (4.9) in AA controls versus the AE cells (n = 20 comparisons) and 5.1 (2.1) in AA controls versus the EE cells (n = 22 comparisons). This indicated preferential invasion of the normal cells and was reflected in significantly reduced susceptibility ratios for the thalassemic cells. The median (range) SR of all the RBCs with abnormal hemoglobin (n = 109) was significantly lower 0.40 (0.08-0.98) than that of the normal RBCs (P = .01). The median (range) SR of HbEE RBCs, 0.69 (0.13-0.98), was significantly higher than that of HbAE RBCs, 0.34 (0.05-0.64); HbH, 0.28 (0.11-0.78); HbHCS (Constant Spring), 0.3 (0.11-0.8); and β-thalassemia/HbE; 0.32 (0.08-0.84), P ≤ .01 (Figure2). The median (range) 0.31 (0.1-0.69) SR values in 17 subjects with β-thalassemia/HbE who had previously undergone splenectomy was slightly lower than in the 28 individuals with intact spleens P = .33 (0.1-0.8). The SR of parasitized HRBCs was not associated with the MCV or MCH (r = 0.02,P = .88 and r = 0.06, P = .6, respectively), and there was also no correlation between SR and either MCV or MCH (r = 0.07, P = .54 and r = −0.02,P = .84, respectively).
The relative susceptibility ratio (SR) to
P falciparum malaria of abnormal hemoglobin RBCs. AA indicates HbAA; HbAE, HbE heterozygote; βE, β-thalassemia/HbE; EE, HbE homozygote; H, HbH disease; HCS, HbH/Constant Spring). – • – represents median and 95% CI.
The relative susceptibility ratio (SR) to
P falciparum malaria of abnormal hemoglobin RBCs. AA indicates HbAA; HbAE, HbE heterozygote; βE, β-thalassemia/HbE; EE, HbE homozygote; H, HbH disease; HCS, HbH/Constant Spring). – • – represents median and 95% CI.
Selectivity indices
To determine whether the reduced invasion rates in abnormal hemoglobinopathic RBCs resulted from increased selectivity (a reduced proportion of susceptible RBCs) or a generalized resistance to invasion, we counted the number of RBCs containing more than one parasite and compared these with the expected value from the Poisson distribution to obtain the SI as described above. Because the parasitemia of the HRBCs was lower than in those RBCs with normal hemoglobin, the expected number of multiply invaded RBCs was also lower. To accommodate for systematic counting errors, and thus ensure the coefficient of variation for the counting of multiple invaded RBCs was the same for both normal and abnormal hemoglobin RBCs, more parasitized abnormal RBCs (500 cells) were counted. The median (range) SI of abnormal RBCs, 0.91 (0-20), was significantly higher than that of normal RBCs, 0.47 (0-2.3; P < .001) as shown in Figure3. When the SI values were compared among the different hemoglobin types, the difference was found to result mainly from the high SI for AE cells. The median (range) SI of HbAE RBCs, 3.85 (1-15), was significantly higher than those of HbH RBCs, 1.15 (0.32-6.25); HbCS, 0.92 (0.34-5); β-thalassemia/HbE, 0.9 (0-7); and HbEE, 0.75 (0.35-0.9) (P ≤ .01). There were no associations between SI and MCV or MCH (r = −0.13,P = .028 and r = −0.12, P = .38, respectively). The surface areas of the RBCs were calculated from MCV, but there was no association between surface area and invasion susceptibility (both SR and SI; P = .175 andP = .19, respectively).
SI of abnormal hemoglobin RBCs from 109 individuals.
AA indicates HbAA; HbAE, HbE heterozygote; βE, β-thalassemia/HbE; EE, HbE homozygote; H, HbH disease; HCS, HbH/Constant Spring. – • – represents median and 95% CI.
SI of abnormal hemoglobin RBCs from 109 individuals.
AA indicates HbAA; HbAE, HbE heterozygote; βE, β-thalassemia/HbE; EE, HbE homozygote; H, HbH disease; HCS, HbH/Constant Spring. – • – represents median and 95% CI.
Discussion
Abundant epidemiologic evidence suggests that certain genetic disorders of RBCs have been selected because they confer protection from malaria.21-27 However, it has proved difficult to show in the laboratory exactly how this protective mechanism operates. Erythrocytes containing sickle cell hemoglobin retard parasite maturation and thus reduce multiplication.28-30P falciparum grows slowly in homozygous HbE RBCs, but not in heterozygous RBCs.7,31 In hereditary ovalocytosis, there is both increased membrane rigidity and a hostile intraerythrocytic milieu.32 The increased amounts of hemoglobin F present in patients with some hemoglobinopathies is also associated with impaired malaria parasite growth.33-35 Some studies,36,37 but not others,38 have shown greatly reduced cytoadherence and rosette formation by α- and β-thalassemic RBCs infected with P falciparum. Other studies39,40 have shown that parasitized α- and β-thalassemic RBCs preferentially bind surface antibody, which would be expected to enhance their clearance. There is also evidence for enhanced immune clearance in sickle cell trait.41 Recent epidemiologic studies12 in the South Pacific island republic of Vanuatu provide a new twist in this tale. Children with α-thalassemia had more malaria in the first years of life compared with children who had normal hemoglobin types. P vivax was a common infection and it was suggested that coinfection or previous infection with this parasite may attenuate the severity of the more virulent P falciparum malaria.42 Thus, it is still uncertain whether α-thalassemic RBCs facilitate or inhibit parasite invasion or multiplication.
In this study, evidence is presented that certain genetic RBC abnormalities, prevalent in Thailand, are associated with reduced parasite invasion when starting parasite densities are high (1%). This reflects the situation on the threshold of developing severe malaria. RBCs from patients with most of the hemoglobinopathies represented in this study are functionally abnormal. The general susceptibility ratios observed in these abnormal cells were lower than those of normal cells suggesting a process affecting all the cells. These dysfunctional cells may not have withstood ex vivo culture conditions as well as their normal counterparts and this may have resulted in membrane changes that led to reduced parasite invasion. Thus, the in vivo relevance of these findings is uncertain. Heterozygote AE cells, although they are microcytic and contain less hemoglobin, are generally considered to be functionally relatively normal, and so the finding that invasion was reduced more in these cells than in homozygous EE cells is surprising and likely to be of clinical relevance. This suggests a membrane abnormality and cannot be related to poor intraerythrocytic growth. Hemoglobin E is common in Southeast Asia. Epidemiologic studies have been divided as to whether hemoglobin E protects from malaria infection9,10 although recent evidence from clinical studies indicates that this hemoglobin type does confer protection from severe malaria.11
Earlier studies were also divided on whether hemoglobin E reduced parasite multiplication.7 31 The multiplication rates observed in this study are not strictly comparable with earlier data for 2 reasons. First, the abnormal cells were mixed with normal cells providing an alternative for merozoite invasion, and second we chose to examine a single cycle and to start at a relatively high parasite count (1%). The earlier studies started at counts approximately 10 times lower and averaged the counts over 2 cycles. This may overestimate considerably the count in the second cycle because multiplication falls as parasite densities rise over 1%. Yet this is the range of parasite counts of greater relevance to severe malaria. Interestingly, multiplication rates in normal (AA) cells were significantly higher when mixed with thalassemic cells compared to mixture with other AA cells. This indicates that merozoite release was unaffected by the type of surrounding RBCs, but that there was preferential invasion of normal cells by the liberated merozoites.
The reduction in RBC invasion in HbAE heterozygotes was associated with a 4-fold increase in the selectivity index compared the other hemoglobin types studied and in particular the EE homozygotes. This is a reflection of the proportion of the RBC population that can be invaded and suggests that in heterozygote individuals with AE hemoglobin, only a quarter of the RBC population can be invaded byP falciparum. This was very different from the findings with RBCs with the other hemoglobin types in this study. It would be expected to limit the potential for parasite multiplication and thus attenuate the expansion of the P falciparum malaria infection, particularly at high parasitemias. It may also explain some previous inconsistencies in the literature. If invasion is restricted to only a subpopulation of the RBC population, then parasite densities will be affected only at high values. Multiplication at lower densities, and thus the incidence of malaria, would not be affected greatly, but the heavy parasitemias that are associated with severe malaria would be prevented. This is analogous to the situation withP vivax where invasion is restricted to only 13% of the RBC population (based on RBC age)13 and severe malaria is very rare. Thus, the protection conferred by AE cells may operate against severe rather than uncomplicated malaria.
These data suggest an unidentified surface, or membrane difference, in these heterozygote cells. Previous studies showing increased human monocyte phagocytosis of HbAE cells infected with P falciparum also led to a suggestion of a membrane abnormality in these cells.43 Potential factors that reduce the probability of invasion by P falciparum include differences in membrane rigidity and in particular in glycophorin and sialic acid content. It would be of interest to determine whether RBC age is the factor determining invasion in AE cells. This study suggests that the genetics of hemoglobin E may be explained by a balanced polymorphism in which the deleterious effects of the homozygote condition are offset by the protection against high parasitemias and thus severe malaria conferred by the heterozygote.
We would like to thank to Mr Narongchai Tongyoo, Miss Bongkot Soonthornsata, and Miss Mayuree Chimweset for their help in the laboratory. We are very grateful to Sir David Weatherall for his comments and advice.
This work was a part of the Wellcome Trust-Mahidol University-Oxford Tropical Medicine Research Programme funded by the Wellcome Trust of Great Britain.
The publication costs of this article were defrayed in part by page charge payment. Therefore, and solely to indicate this fact, this article is hereby marked “advertisement” in accordance with 18 U.S.C. section 1734.
References
Author notes
Nicholas White, Faculty of Tropical Medicine, Mahidol University, 420/6 Rajvithi, Bangkok, Thailand; e-mail:fnnjw@diamond.mahidol.ac.th.